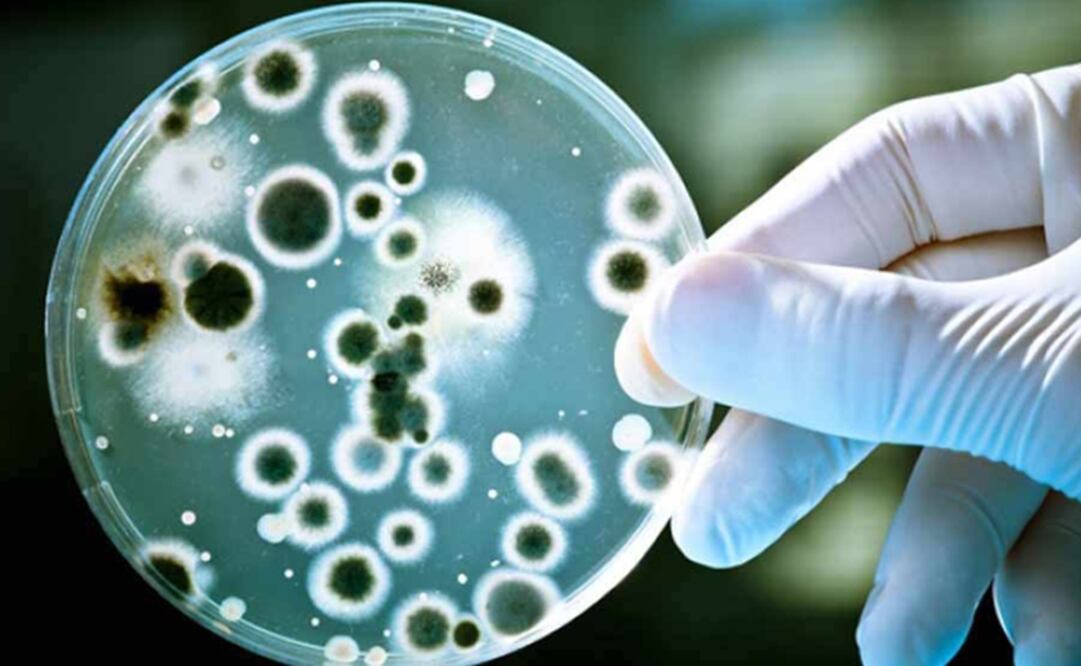
(FOTO: Especial)

Investigadores del Instituto de Ciencias Físicas (ICF) de la UNAM, junto con académicos de la Universidad Autónoma del Estado de Morelos (UAEM) y del Centro de Investigaciones y Estudios Avanzados (Cinvestav), desarrollaron una molécula derivada de la Anfotericina B , más potente que este antibiótico frente a las enfermedades micóticas , pero con menos toxicidad colateral.
Denominada “A21”, ya se ha comprobado en pruebas preclínicas. Actualmente se trabaja con autoridades sanitarias y farmacéuticas para que una vez fabricado con calidad farmacéutica pueda probarse en humanos, expuso el investigador del ICF, Iván Ortega.
Luego de aproximadamente 15 años de investigación, y de una solicitud de patente desde diciembre de 2010 –con 20 años de vigencia en México, Estados Unidos y otras naciones–, este proyecto seguirá adelante al ser uno de los 13 que conforman el Consorcio Nacional de Investigación en MedicinaTraslacional e Innovación .
Este organismo fue creado en abril pasado entre la UNAM, el Consejo Nacional de Ciencia y Tecnología (Conacyt) y la Secretaría de Salud federal para sumar fortalezas y recursos en torno a investigaciones en salud que puedan ser utilizadas en un mejor tratamiento para los pacientes, agregó Gloria Soberón Chávez, directora General de Vinculación de la Coordinación de Innovación y Desarrollo.
Ortega, integrante del Sistema Nacional de Investigadores (SNI) nivel III, recordó que iniciaron el trabajo con la Anfotericina B –la droga madre- al tratar de entender cómo funcionaba y qué hacía. “En este esfuerzo terminamos sintetizando una molécula nueva, un derivado que es tan efectivo como la Anfotericina B en el ataque a los hongos, pero mucho menos tóxica a los mamíferos”.
La Anfotericina B
, producida por la bacteria Streptomyses nodosus, se ha usado terapéuticamente por mucho tiempo contra enfermedades de micosis oportunistas, como las que podrían presentarse en una inmunodepresión por sida o cáncer, ejemplificó. El problema es que al microorganismo no le importa si además de exterminar al hongo mata a los mamíferos.
Para llegar al desarrollo de la molécula, el universitario y sus colaboradores tuvieron que pasar de los estudios de electrofisiología a los de síntesis orgánica, microbiología, dinámica molecular y, posteriormente, relacionarse con investigadores de la Facultad de Estudios Superiores (FES) Zaragoza , quienes ayudaron a producir cantidades mayores de la molécula para realizar pruebas preclínicas y probar su efectividad.
Al respecto, Soberón Chávez comentó que para acelerar este proceso también se han acercado al Instituto Nacional de Cancerología (INCan). “La idea es que una vez que se cuente con alguien autorizado por la Comisión Federal para la Protección contra Riesgos Sanitarios (Cofepris) para elaborar el antibiótico, se realicen las pruebas clínicas del medicamento entre pacientes del INCan”.
jpe
Noticias según tus intereses
[Publicidad]
[Publicidad]